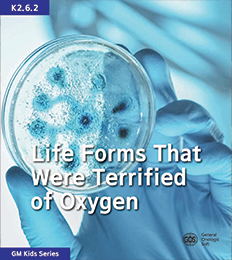

개인정보 취급방침
개인정보 처리방침에 대한 내용을 입력하십시오.
이용약관
서비스 이용약관에 대한 내용을 입력하십시오.
K2 시리즈 96
Topic K2.1
Topic K2.2
Topic K2.3
Topic K2.4
Topic K2.5
Topic K2.6
Topic K2.7
Topic K2.8
Topic K2.9
Topic K2.10
Topic K2.11
Topic K2.12
Topic K2.1
무한한 시간과 물질의 공간인 우주는 무엇일까요?
좌우 스크롤시 표 전체 내용을 확인할 수 있습니다.
| 책 코드 | 제목 | ISBN | 가격 |
|---|---|---|---|
| K2.1.1 | 우주는 어떻게 태어났을까요? | 979-8-89533-000-5 | $13 |
| K2.1.2 | 우주에는 무엇이 살고 있을까요? | 979-8-89533-001-2 | $13 |
| K2.1.3 | 해와 별은 어떻게 태어났을까요? | 979-8-89533-002-9 | $13 |
| K2.1.4 | 지구는 어떻게 태어났을까요? | 979-8-89533-003-6 | $13 |
| K2.1.5 | 달은 어떻게 태어났을까요? | 979-8-89533-004-3 | $13 |
| K2.1.6 | 지구의 공기는 어떻게 만들어졌을까요? | 979-8-89533-005-0 | $13 |
| K2.1.7 | 지구 속에는 무엇이 들어 있을까요? | 979-8-89533-006-7 | $13 |
| K2.1.8 | 지구의 생명체는 어떻게 태어났을까요? | 979-8-89533-007-4 | $13 |
Topic K2.2
지구 최초의 생명체, 루카야! 안녕



좌우 스크롤시 표 전체 내용을 확인할 수 있습니다.
| 책 코드 | 제목 | ISBN | 가격 |
|---|---|---|---|
| K2.2.1 | 물은 어디서 왔을까요? | 979-8-89533-064-7 | $13 |
| K2.2.2 | 바다는 어떻게 만들어졌을까요? | 979-8-89533-065-4 | $13 |
| K2.2.3 | 유기물은 무엇일까요? | 979-8-89533-066-1 | $13 |
| K2.2.4 | 지구 최초의 생명체, 루카가 태어났어요 | 979-8-89533-067-8 | $13 |
| K2.2.5 | 어떻게 세균으로 발전했을까요? | 979-8-89533-068-5 | $13 |
| K2.2.6 | 핵을 가진 생명체가 나타났어요 | 979-8-89533-069-2 | $13 |
| K2.2.7 | 공룡이 왔다가 사라졌어요 | 979-8-89533-070-8 | $13 |
| K2.2.8 | 드디어, 포유류가 나타났어요 | 979-8-89533-071-5 | $13 |
Topic K2.3
생명체는 어떤 환경에서 살 수 있을까요?



좌우 스크롤시 표 전체 내용을 확인할 수 있습니다.
| 책 코드 | 제목 | ISBN | 가격 |
|---|---|---|---|
| K2.3.1 | 세상에 물이 없다면 어떻게 될까요? | 979-8-89533-080-7 | $13 |
| K2.3.2 | 산소는 왜 필요할까요? | 979-8-89533-081-4 | $13 |
| K2.3.3 | 공기는 어떤 역할을 할까요? | 979-8-89533-082-1 | $13 |
| K2.3.4 | 온도는 왜 중요할까요? | 979-8-89533-083-8 | $13 |
| K2.3.5 | 에너지는 어디에서 왔을까요? | 979-8-89533-084-5 | $13 |
| K2.3.6 | 대기 속에는 어떤 친구들이 모여 있을까요? | 979-8-89533-085-2 | $13 |
| K2.3.7 | 비와 눈, 바람은 어디에서 생겨났을까요? | 979-8-89533-086-9 | $13 |
| K2.3.8 | 오존층이 없다면 무슨 일이 생길까요? | 979-8-89533-087-6 | $13 |
Topic K2.4
동물들은 뛰면서 살아남을 수 있어요



좌우 스크롤시 표 전체 내용을 확인할 수 있습니다.
| 책 코드 | 제목 | ISBN | 가격 |
|---|---|---|---|
| K2.4.1 | 인간은 어떻게 두 발로 걷기 시작했을까요? | 979-8-89533-160-6 | $13 |
| K2.4.2 | 올챙이는 어떻게 개구리가 되었을까요? | 979-8-89533-161-3 | $13 |
| K2.4.3 | 강아지는 얼마나 빨리 달릴 수 있을까요? | 979-8-89533-162-0 | $13 |
| K2.4.4 | 말은 언제까지 달릴 수 있을까요? | 979-8-89533-163-7 | $13 |
| K2.4.5 | 방아벌레는 어떻게 높이 뛰어오를까요? | 979-8-89533-164-4 | $13 |
| K2.4.6 | 타조는 왜 날지 못하고 뛰게 되었을까요? | 979-8-89533-165-1 | $13 |
| K2.4.7 | 아기 주머니 캥거루는 어떻게 뛸 수 있을까요? | 979-8-89533-166-8 | $13 |
| K2.4.8 | 세상에서 가장 빠른 동물은 무엇일까요? | 979-8-89533-167-5 | $13 |
Topic K2.5
최초의 식물은 언제, 어디서 어떻게 나타났을까요?



좌우 스크롤시 표 전체 내용을 확인할 수 있습니다.
| 책 코드 | 제목 | ISBN | 가격 |
|---|---|---|---|
| K2.5.1 | 태초에 지구는 어떤 모습이었을까요? | 979-8-89533-176-7 | $13 |
| K2.5.2 | 지구에 반가운 식물이 찾아왔어요 | 979-8-89533-177-4 | $13 |
| K2.5.3 | 산소가 식물에게 큰 도움을 줬어요 | 979-8-89533-178-1 | $13 |
| K2.5.4 | 광합성 세균이 나타났어요 | 979-8-89533-179-8 | $13 |
| K2.5.5 | 식물은 물속에서 태어났어요 | 979-8-89533-180-4 | $13 |
| K2.5.6 | 식물이 땅으로 올라왔어요 | 979-8-89533-181-1 | $13 |
| K2.5.7 | 남조식물은 세균과 가까이 살았어요 | 979-8-89533-182-8 | $13 |
| K2.5.8 | 화석은 식물의 비밀을 쥐고 있어요 | 979-8-89533-183-5 | $13 |
Topic K2.6
최초의 동물은 언제, 어디서 어떻게 나타났을까요?

좌우 스크롤시 표 전체 내용을 확인할 수 있습니다.
| 책 코드 | 제목 | ISBN | 가격 |
|---|---|---|---|
| K2.6.1 | 산소가 없어도 살 수 있었던 생물들 | 979-8-89533-384-6 | $13 |
| K2.6.2 | 산소의 등장이 너무도 무서웠던 생물들 | 979-8-89533-385-3 | $13 |
| K2.6.3 | 세균이 맨 먼저 산소를 이용했어요 | 979-8-89533-386-0 | $13 |
| K2.6.4 | 고세균은 원핵세포로 이루어졌어요 | 979-8-89533-387-7 | $13 |
| K2.6.5 | 진핵생물은 언제 어떻게 등장했어요? | 979-8-89533-388-4 | $13 |
| K2.6.6 | 그리파니아 화석 속에 들어 있는 비밀 | 979-8-89533-389-1 | $13 |
| K2.6.7 | 로디니아 대륙이 사라지고 곤드와나 대륙이 만들어졌어요 | 979-8-89533-390-7 | $13 |
| K2.6.8 | 산소는 단세포 생물의 세상을 열었어요 | 979-8-89533-391-4 | $13 |
Topic K2.7
인류의 역사를 바꾼 위대한 사건들을 알아봐요



좌우 스크롤시 표 전체 내용을 확인할 수 있습니다.
| 책 코드 | 제목 | ISBN | 가격 |
|---|---|---|---|
| K2.7.1 | 인간은 왜 두 발로 걷게 되었을까요? | 979-8-89533-228-3 | $13 |
| K2.7.2 | 인류는 언제부터 돌 도구를 사용했을까요? | 979-8-89533-229-0 | $13 |
| K2.7.3 | 인류는 왜 아프리카를 탈출했을까요? | 979-8-89533-230-6 | $13 |
| K2.7.4 | 인류는 어떻게 불을 사용하게 되었을까요? | 979-8-89533-231-3 | $13 |
| K2.7.5 | 최초로 요리를 했던 인류는 누구였을까요? | 979-8-89533-248-1 | $13 |
| K2.7.6 | 인류는 왜 옷을 만들어 입었을까요? | 979-8-89533-249-8 | $13 |
| K2.7.7 | 인류는 언제부터 사랑에 눈을 떴을까요? | 979-8-89533-250-4 | $13 |
| K2.7.8 | 현생 인류의 조상은 누구였을까요? | 979-8-89533-251-1 | $13 |
Topic K2.8
쌀과 밀이 만들어 준 인류 문명의 비밀



좌우 스크롤시 표 전체 내용을 확인할 수 있습니다.
| 책 코드 | 제목 | ISBN | 가격 |
|---|---|---|---|
| K2.8.1 | 벼농사는 언제부터 짓기 시작했을까요? | 979-8-89533-272-6 | $13 |
| K2.8.2 | 쌀로 요리할 수 있는 음식에는 어떤 것들이 있을까요? | 979-8-89533-273-3 | $13 |
| K2.8.3 | 밀농사는 언제부터 짓기 시작했을까요? | 979-8-89533-274-0 | $13 |
| K2.8.4 | 밀로 요리할 수 있는 음식에는 어떤 것들이 있을까요? | 979-8-89533-275-7 | $13 |
| K2.8.5 | 동양 사람들은 왜 밥을 먹게 되었을까요? | 979-8-89533-276-4 | $13 |
| K2.8.6 | 서양 사람들은 왜 빵을 먹게 되었을까요? | 979-8-89533-277-1 | $13 |
| K2.8.7 | 밥을 먹는 사람들에게 공동체는 왜 중요했을까요? | 979-8-89533-278-8 | $13 |
| K2.8.8 | 빵을 먹는 사람들에게 자유는 왜 중요했을까요? | 979-8-89533-279-5 | $13 |
Topic K2.9
자연의 생존 방식, 식물의 숨겨진 언어를 알아봐요



좌우 스크롤시 표 전체 내용을 확인할 수 있습니다.
| 책 코드 | 제목 | ISBN | 가격 |
|---|---|---|---|
| K2.9.1 | 식물은 곤충의 공격을 어떻게 피할까요? | 979-8-89533-292-4 | $13 |
| K2.9.2 | 식물은 스트레스를 어떻게 이겨낼까요? | 979-8-89533-293-1 | $13 |
| K2.9.3 | 식물의 뿌리는 어떤 역할을 할까요? | 979-8-89533-294-8 | $13 |
| K2.9.4 | 식물의 꽃은 어떤 역할을 할까요? | 979-8-89533-295-5 | $13 |
| K2.9.5 | 식물은 어떻게 소리를 들을까요? | 979-8-89533-316-7 | $13 |
| K2.9.6 | 식물은 촉감을 가지고 있을까요? | 979-8-89533-317-4 | $13 |
| K2.9.7 | 식물은 냄새를 맡을 수 있을까요? | 979-8-89533-328-0 | $13 |
| K2.9.8 | 식물은 지능을 가지고 있을까요? | 979-8-89533-329-7 | $13 |
Topic K2.10
식물은 어떻게 생존을 유지하고 종족을 보존할 수 있을까요?



좌우 스크롤시 표 전체 내용을 확인할 수 있습니다.
| 책 코드 | 제목 | ISBN | 가격 |
|---|---|---|---|
| K2.10.1 | 식물은 왜 아름다운 꽃을 피울까요? | 979-8-89533-330-3 | $13 |
| K2.10.2 | 식물에게는 왜 햇빛이 필요할까요? | 979-8-89533-331-0 | $13 |
| K2.10.3 | 지구상에는 왜 속씨식물이 많을까요? | 979-8-89533-332-7 | $13 |
| K2.10.4 | 은행나무는 왜 화석 식물이 되었을까요? | 979-8-89533-333-4 | $13 |
| K2.10.5 | 꽃가루받이에 유리한 식물은 무엇일까요? | 979-8-89533-334-1 | $13 |
| K2.10.6 | 식물이 열매를 맺는 이유는 무엇일까요? | 979-8-89533-335-8 | $13 |
| K2.10.7 | 익기 전 식물의 열매는 왜 녹색일까요? | 979-8-89533-336-5 | $13 |
| K2.10.8 | 식물은 살아남기 위해 어떻게 씨를 퍼뜨릴까요? | 979-8-89533-337-2 | $13 |
Topic K2.11
그리스 신화 속에 들어 있는 인간의 사고방식



좌우 스크롤시 표 전체 내용을 확인할 수 있습니다.
| 책 코드 | 제목 | ISBN | 가격 |
|---|---|---|---|
| K2.11.1 | 하늘과 땅을 주관하고 인간을 지키는 제우스 | 979-8-89533-321-1 | $13 |
| K2.11.2 | 결혼과 출산을 관장하는 헤라 | 979-8-89533-343-3 | $13 |
| K2.11.3 | 미와 사랑을 주관하는 아프로디테 | 979-8-89533-344-0 | $13 |
| K2.11.4 | 곡물과 농업 기술을 관장하는 데메테르 | 979-8-89533-322-8 | $13 |
| K2.11.5 | 죽은 사람의 망령을 저승으로 인도하는 헤르메스 | 979-8-89533-323-5 | $13 |
| K2.11.6 | 자연의 생성과 포도주를 다스리는 디오니소스 | 979-8-89533-345-7 | $13 |
| K2.11.7 | 바다와 강, 우물을 지배하는 포세이돈 | 979-8-89533-346-4 | $13 |
| K2.11.8 | 음악과 의료, 시를 관장하는 아폴론 | 979-8-89533-347-1 | $13 |
Topic K2.12
인류 문명을 이끌어 온 숫자의 탄생과 발전 과정



좌우 스크롤시 표 전체 내용을 확인할 수 있습니다.
| 책 코드 | 제목 | ISBN | 가격 |
|---|---|---|---|
| K2.12.1 | 가장 오래된 수학의 유물, 레봄버뼈는 무엇일까요? | 979-8-89533-364-8 | $13 |
| K2.12.2 | 인류 최초로 시간을 측정했던 이상고뼈는 무엇일까요? | 979-8-89533-365-5 | $13 |
| K2.12.3 | 구석기 시대에 사용했던 계산막대란 무엇일까요? | 979-8-89533-366-2 | $13 |
| K2.12.4 | 신석기 시대에는 어떤 계산 도구가 필요했을까요? | 979-8-89533-367-9 | $13 |
| K2.12.5 | 바빌로니아에서는 어떤 숫자 체계가 등장했을까요? | 979-8-89533-368-6 | $13 |
| K2.12.6 | 고대 이집트 왕국에서는 어떤 숫자를 사용했을까요? | 979-8-89533-369-3 | $13 |
| K2.12.7 | 왜 피타고라스가 그리스 수학의 아버지가 되었을까요? | 979-8-89533-370-9 | $13 |
| K2.12.8 | 최초의 이진법과 로마 숫자는 어떻게 탄생했을까요? | 979-8-89533-371-6 | $13 |



